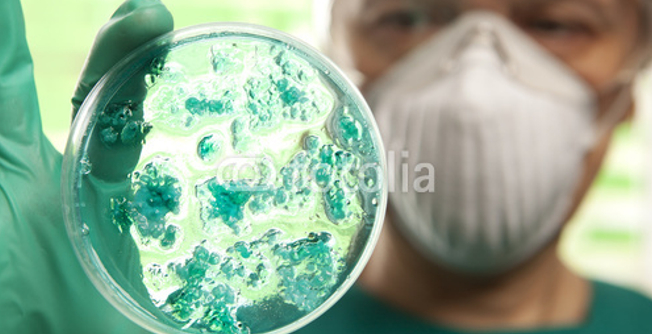
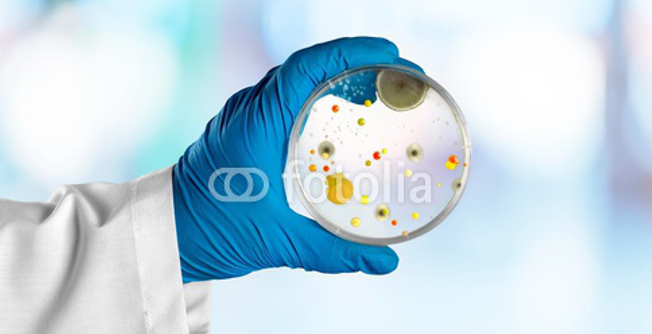

FUNDACJA
NA RZECZ ZWALCZANIA CHORÓB ZAKAŹNYCH
NA RZECZ ZWALCZANIA CHORÓB ZAKAŹNYCH

AKTUALNOŚCI
Lorem ipsum dolor sit amet, ex elit ea consectetuer adipiscing elit, sed diam nonummy nibh euismod tincidunt ut et laoreet dolore magna aliquam erat nisl volutpat. Ut wisi enim ad minim veniam, quis nostrud exerci tation ullamcorper suscipit lobortis nisl ut aliquip ex ea commodo consequat.
Lorem ipsum dolor sit amet, ex elit ea consectetuer adipiscing elit, sed diam nonummy nibh euismod tincidunt ut et laoreet dolore magna aliquam erat nisl volutpat. Ut wisi enim ad minim veniam, quis nostrud exerci tation ullamcorper suscipit lobortis nisl ut aliquip ex ea commodo consequat.
WITAMY NA NASZEJ STRONIE
Lorem ipsum dolor sit amet, ex elit ea consectetuer adipiscing elit, sed diam nonummy nibh euismod tincidunt ut et laoreet dolore magna aliquam erat nisl volutpat. Ut wisi enim ad minim veniam, quis nostrud exerci tation ullamcorper suscipit lobortis nisl ut aliquip ex ea commodo consequat. Lorem ipsum dolor sit amet, magna ex consectetuer adipiscing elit, sed diam nonummy nibh euismod tincidunt ut et laoreet dolore magna aliquam erat ex ea volutpat. Ut wisi enim ad minim veniam, quis nostrud exerci tation ullamcorper suscipit lobortis nisl ut aliquip ex ea commodo magna ex consectetuer consequat.
Lorem ipsum dolor sit amet, ex elit ea consectetuer adipiscing elit, sed diam nonummy nibh euismod tincidunt ut et laoreet dolore magna aliquam erat nisl volutpat. Ut wisi enim ad minim veniam, quis nostrud exerci tation ullamcorper suscipit lobortis nisl ut aliquip ex ea commodo consequat. Lorem ipsum dolor sit amet, magna ex consectetuer adipiscing elit, sed diam nonummy nibh euismod tincidunt ut et laoreet dolore magna aliquam erat ex ea volutpat. Ut wisi enim ad minim veniam, quis nostrud exerci tation ullamcorper suscipit lobortis nisl ut aliquip ex ea commodo magna ex consectetuer consequat.

Copyright © 2015 by "YACOOB" • All Rights reserved • E-Mail: yacoob@box.com.pl